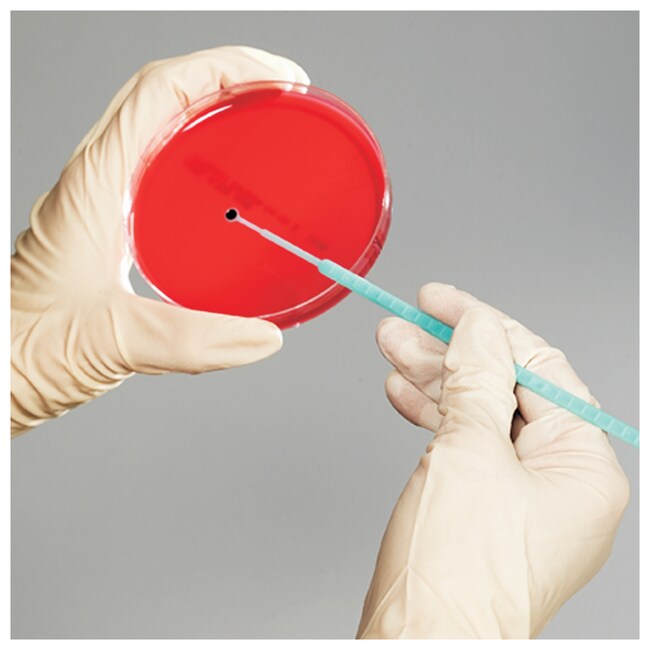

Search
Search
| 產品號碼 | Quantity |
|---|---|
| R4721000 | 100 Tests/Set |
Thermo Scientific™ Quanti-Cult Plus Growth Promotion Testing Set is supplied as a film of preserved microorganisms on the inside of the cap on a plastic vial ready for rehydration and use in quality control procedures.
Includes:
10 preserved organism vials and 10 rehydration vials
Contents:
Aspergillus brasiliensis ATCC™ 16404™
Bacillus subtilis ATCC™ 6633™
Candida albicans ATCC™ 10231™
Clostridium sporogenes ATCC™ 11437™
Pseudomonas aeruginosa ATCC™ 9027™.